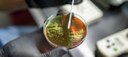

Notícias TV

Água: Brasil piora índice de perdas na distribuição
— por Antônio Luiz Moreira Bezerra — última modificação 21/05/2024 11h10O aumento no indicador foi de dois pontos percentuais, aponta estudo do Trata Brasil.

Prazo de adesão ao desenrola Brasil não é prorrogado, informa Fazenda
— por Antônio Luiz Moreira Bezerra — última modificação 21/05/2024 15h01Prorrogação da MP não altera data de adesão ao programa.

Detentos recebem em Teresina mutirão de atendimentos multidisciplinares
— por Antônio Luiz Moreira Bezerra — última modificação 21/05/2024 14h55Os internos recebem avaliação completa da equipe de enfermagem.

G20 - 52 delegações internacionais se reúnem em Teresina nesta quarta (22)
— por Antônio Luiz Moreira Bezerra — última modificação 21/05/2024 11h32As reuniões também busca fomentar o turismo e o intercâmbio cultural.

Saúde defende escuta humanizada no acolhimento de vítimas de desastres
— por Antônio Luiz Moreira Bezerra — última modificação 21/05/2024 11h02Ministério lança publicações com recomendações emergenciais.

Mata Atlântica: desmatamento cai em áreas contínuas entre 2022 e 2023
— por Antônio Luiz Moreira Bezerra — última modificação 21/05/2024 10h41Há diminuição do desmatamento em grande parte de 17 estados, com exceção de Piauí, Ceará, de Mato Grosso do Sul e Pernambuco.

Desenrola Brasil tem prazo de adesão prorrogado por mais 60 dias
— por Antônio Luiz Moreira Bezerra — última modificação 21/05/2024 10h31Nova prorrogação foi aprovada pelo Congresso.

9 milhões de MEIs precisam entregar declaração do Simples Nacional
— por Antônio Luiz Moreira Bezerra — última modificação 21/05/2024 10h22Prazo encerra em 31 de maio para MEIs de todo o país, com exceção do Rio Grande do Sul.

Tudo pronto para a V Jornada Piauiense de Dermatologia
— por Antônio Luiz Moreira Bezerra — última modificação 21/05/2024 09h36o evento será realizado nos dias 24 e 25 deste mês.

Conheça nova proposta sobre divórcio unilateral direto no cartório
— por Antônio Luiz Moreira Bezerra — última modificação 21/05/2024 09h25A advogada familiarista Isabela Paranaguá participa de entrevista no Jornal Bom Dia Alepi e dá mais detalhes sobre o tema.

Pesquisa revela salto do Piauí no IDH, PIB, expectativa de vida e redução da pobreza
— por Antônio Luiz Moreira Bezerra — última modificação 21/05/2024 08h20O estudo realizado pelo Pnud apontou, ainda, os avanços nos índices educacionais e de saúde.

TRT-22 inicia 8ª Semana Nacional da Conciliação Trabalhista
— por Antônio Luiz Moreira Bezerra — última modificação 21/05/2024 08h11Evento segue até sexta-feira (24/5) com o tema “É conciliando que a gente se entende”.

III Encontro Regional de Trabalho do TJ-PI terá palestra de Oscar Schmidt e mesas temáticas
— por Antônio Luiz Moreira Bezerra — última modificação 21/05/2024 08h04O evento ocorrerá entre os dias de 22 a 24 de maio, em Teresina.

Tragédia no RS traz debate sobre adaptação às mudanças climáticas
— por Antônio Luiz Moreira Bezerra — última modificação 20/05/2024 20h05Cidades precisam pensar em adaptações para conviver com a natureza.

Brasil: 94% dos municípios já sofreram emergência ou calamidade
— por Antônio Luiz Moreira Bezerra — última modificação 20/05/2024 19h58Pesquisa foi feita por confederação dos municípios entre 2013 e 2023.

OMS atualiza lista de bactérias que mais ameaçam a saúde humana
— por Antônio Luiz Moreira Bezerra — última modificação 20/05/2024 19h51Levantamento faz parte dos esforços para conter a resistência antimicrobiana.

Batata, banana, laranja e melancia estão mais baratas, segundo a Conab
— por Antônio Luiz Moreira Bezerra — última modificação 20/05/2024 19h42Cenário é de preço menor também para a banana.

Barragens geridas pelo Idepi garantem segurança hídrica após período chuvoso
— por Antônio Luiz Moreira Bezerra — última modificação 20/05/2024 15h34Seis reservatórios ainda sangram e nove estão próximos da capacidade máxima.

Piauí é exemplo no combate à fome, afirma Rafael durante o G20 Social em Teresina
— por Antônio Luiz Moreira Bezerra — última modificação 20/05/2024 15h39Evento também ocorre na capital piauiense entre os dias 22 e 24 de maio.

Menores de 14 anos não podem namorar
— por Antônio Luiz Moreira Bezerra — última modificação 20/05/2024 15h14Em entrevista ao Jornal Alepi TV 1, a advogada familiarista Suéllen Pinheiro explica sobre o assunto.

IFPI abre inscrições para cursos técnicos
— por Antônio Luiz Moreira Bezerra — última modificação 20/05/2024 14h59Em entrevista ao Jornal Alepi TV 1, o diretor-geral IFPI Campus Sul, Germano Lúcio, dá mais informações.

TST vai definir modo como trabalhadores podem rejeitar cobrança a sindicatos
— por Antônio Luiz Moreira Bezerra — última modificação 20/05/2024 11h37Especialistas afirmam que há ausência de regras em torno do direito de oposição dos empregados ao desconto no salário.

Fiocruz: vírus sincicial respiratório e influenza A ainda exigem atenção
— por Antônio Luiz Moreira Bezerra — última modificação 20/05/2024 11h31No agregado nacional, há sinal de estabilidade de SRAG.

Brasil tem 15,7 milhões de microempreendedores individuais
— por Antônio Luiz Moreira Bezerra — última modificação 20/05/2024 11h20Número representa 73% dos total de empresas formais do país.

Renovação de cotas enfrenta desafios no Congresso
— por Antônio Luiz Moreira Bezerra — última modificação 20/05/2024 11h08Decorridos 136 anos da Lei Áurea, providências têm se mostrado insuficientes para garantir direitos iguais aos negros.

Piauí conta com mais de 150 atividades na Semana do MEI
— por Antônio Luiz Moreira Bezerra — última modificação 20/05/2024 09h44Consultor do Sebre-PI, Leandro Crateús participou de entrevista no Jornal Bom Dia Assembleia.

Estudo da UFPI estimula o debate e a luta a favor de pessoas LGBTQIA+
— por Antônio Luiz Moreira Bezerra — última modificação 20/05/2024 08h10Pesquisa explora corporalidades trans e sexualidades.

Sesapi promove webinário em comemoração ao Dia Nacional da Luta Antimanicomial
— por Antônio Luiz Moreira Bezerra — última modificação 20/05/2024 07h56O evento com o tema "Manicômios Nunca Mais" ocorrerá na segunda-feira, 20 de maio.

Teresina sedia nesta segunda eventos do G20 Social
— por Antônio Luiz Moreira Bezerra — última modificação 20/05/2024 09h53Haverá reunião sobre segurança alimentar apresentação de pesquisa inédita sobre o desenvolvimento do Piauí.

Campanha busca mobilizar população contra violência sexual infantil
— por Antônio Luiz Moreira Bezerra — última modificação 20/05/2024 07h45Especialistas defendem educação sexual nas escolas.

Semana do MEI é oportunidade para capacitar e profissionalizar pequenos negócios
— por Antônio Luiz Moreira Bezerra — última modificação 20/05/2024 09h19Evento gratuito promovido pelo Sebrae ocorre entre os dias 20 e 24 de maio de forma presencial e online.
OMS atualiza lista de bactérias que mais ameaçam a saúde humana
— por Helorrany Rodrigues da Silva — última modificação 19/05/2024 19h48Levantamento faz parte dos esforços para conter a resistência antimicrobiana, problema de saúde global que coloca sob risco muitos ganhos da medicina moderna; documento atualizado contém 15 famílias de bactérias resistentes a antibióticos agrupadas em categorias de priorização crítica, alta e média.

Escassez grave de vacinas de cólera preocupa OMS
— por Helorrany Rodrigues da Silva — última modificação 19/05/2024 19h44Organização Mundial da Saúde registra alta de casos e mortes em 2024 e diz que resposta à doença é afetada por falta de imunizantes; ressurgimento global da cólera foi classificado com o nível mais alto de emergência; conflitos, urbanização não planejada e alterações climáticas aumentam risco de transmissão.

Conhecimento indígena pode melhorar relação com o meio ambiente
— por Helorrany Rodrigues da Silva — última modificação 19/05/2024 13h41Tese é explicada em estudo publicado em 2021

Anvisa defende manutenção de marco regulatório para cannabis medicinal
— por Antônio Luiz Moreira Bezerra — última modificação 19/05/2024 13h31Relatório aponta necessidade de aprimorar resolução em vigor.

RS firma acordo com ONG para assistência a animais resgatados
— por Helorrany Rodrigues da Silva — última modificação 19/05/2024 10h23Balanço da Defesa Civil mostra que 12.215 animais já foram acolhidos

SANEAMENTO: Cerca de 9 milhões de brasileiros não possuem acesso à rede geral de água tratada
— por Helorrany Rodrigues da Silva — última modificação 19/05/2024 09h59Os dados levam em consideração a totalidade de 74 milhões de moradias brasileiras, aponta Instituto Trata Brasil

Escolas são importantes no combate à LGBTfobia, defendem especialistas
— por Antônio Luiz Moreira Bezerra — última modificação 19/05/2024 09h39No Brasil, a discriminação de pessoas LGBTQIA+ é crime.

Piauí que Produz destaca atrativo para abelhas sem ferrão
— por Helorrany Rodrigues da Silva — última modificação 19/05/2024 09h42O programa da TV Alepi explica sobre a utilização alimentar para a colmeia

Idecan anuncia prorrogação das inscrições do concurso da FMS
— por Helorrany Rodrigues da Silva — última modificação 19/05/2024 09h35Candidatos têm enfrentado dificuldades para se inscrever no concurso da Fundação Municipal de Saúde

Previsão de mais chuvas no RS mantém estado em alerta
— por Antônio Luiz Moreira Bezerra — última modificação 17/05/2024 17h57Esforço das autoridades está em drenar água que segue acumulada.

Moraes suspende resolução do CFM que proíbe assistolia fetal
— por Antônio Luiz Moreira Bezerra — última modificação 17/05/2024 17h53Determinação foi motivada por ação do Psol.

Feito em Casa destaca 22ª edição do Salão do Livro do Piauí 2024
— por Antônio Luiz Moreira Bezerra — última modificação 18/05/2024 15h34O professor Cineas Santos apresenta o programa, que tem participação de outros convidados.

Disque 100 recebe duas denúncias por hora de estupro de vulneráveis
— por Helorrany Rodrigues da Silva — última modificação 18/05/2024 13h47Casos que ocorrem em ambiente familiar são subnotificados

Nova vacina contra Covid-19 é apresentada aos municípios do Piauí
— por Helorrany Rodrigues da Silva — última modificação 18/05/2024 13h31O evento ocorreu de forma virtual e contou com a participação de mais de 265 profissionais de saúde dos municípios piauienses.

Estudo revela efetividade das ações de conservação ambiental
— por Helorrany Rodrigues da Silva — última modificação 18/05/2024 11h19Trabalho analisa 186 pesquisas e 665 ensaios de diferentes países

Taxa de desemprego fica em 7,9%; índice é o menor em 10 anos
— por Antônio Luiz Moreira Bezerra — última modificação 17/05/2024 18h09O Piauí é um dos estados que apresenta menor nível de desocupados.

Casais homoafetivos ainda enfrentam preconceitos para adotar crianças
— por Antônio Luiz Moreira Bezerra — última modificação 17/05/2024 17h37Direitos da população LGBTQI+ são garantidos por decisões do STF.

Seguro obrigatório voltará a ser pago em 2025
— por Antônio Luiz Moreira Bezerra — última modificação 17/05/2024 17h32Nova taxa prevê pagamento de serviços médicos a vítimas de acidentes.

Brasil vai sediar Copa do Mundo Feminina de futebol em 2027
— por Antônio Luiz Moreira Bezerra — última modificação 17/05/2024 17h25Eleição ocorreu na manhã desta sexta-feira, na Tailândia.
Ações do documento